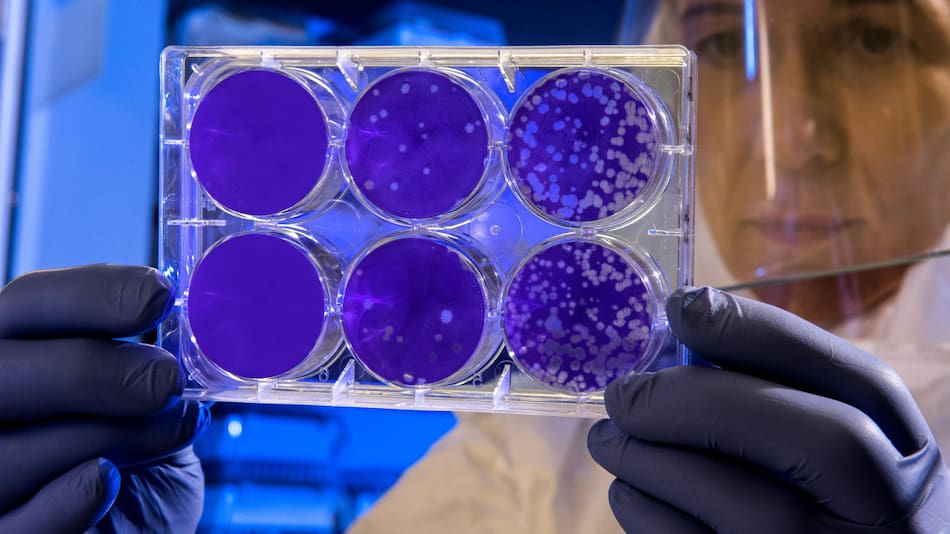

Nuevas estrategias para combatir la resistencia bacteriana a los antibióticos: ¿cómo funcionan?
Un grupo de científicos de la Universidad Nacional de La Plata (UNLP) y de la Universidad de Manitoba en Canadá reveló que las bacterias multirresistentes a los antibióticos tienen sitios vulnerables en su estructura, “blancos” desde dónde pueden ser atacadas. El novedoso hallazgo podría ayudar a combatir a estos microorganismos del complejo Burkholderia cepacia.
El desarrollo de estrategias de combate contra las bacterias en el complejo Burkholderia cepacia son clave en Argentina, ya que estos microorganismos pueden contaminar exitosamente tanques de agua, formulados farmacéuticos y productos que contienen biocidas.
Un artículo publicado en la revista científica Nature Communications por expertos del Centro de Investigación y Desarrollo en Fermentaciones Industriales (CINDEFI), dependiente de la Facultad de Ciencias Exactas de la UNLP y del Conicet descubrió que los antibióticos del grupo de los β-lactámicos son “las armas más poderosas” en la lucha contra estas especies bacterianas.

Antibióticos. Foto: Unsplash
También podría interesarte
Según los expertos, “La envoltura celular de estos organismos constituye una barrera única que impide la penetración de antimicrobianos y son la principal causa de su múltiple resistencia”.
Lo que las vuelve tan resistentes es su amplia distribución, extraordinaria versatilidad metabólica, sus genomas complejos y de gran tamaño, además de una alta tasa de mutación que les permite adaptarse rápidamente a cualquier entorno.
Un peligro para la salud pública
Estos gérmenes también representan un gran problema para la ciudadanía, al causar infecciones crónicas recalcitrantes y multirresistentes en personas con fibrosis quística, en pacientes internado y en personas inmunocomprometidos, indicaron los expertos.

Bacterias. Foto: Unsplash
Las bacterias el complejo Burkholderia cepacia además de ser resistentes a los antibióticos y antisépticos, son capaces de sobrevivir con escasez de nutrientes y alimentarse antimicrobianos como fuente de carbono para sobrevivir.
El estudio publicado en Nature Communications permitió identificar elementos de resistencia y susceptibilidad de estos microorganismos para entender cómo combatirlos.